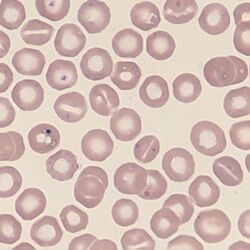

Stomatocytes
From haematologyetc.co.uk
Derivation: Stoma (zoology) “a mouth like opening”Stoma (zoology) “a mouth like opening”
Appearance
The area of central pallor has the form of a “slit” or “mouth”. Depending on the cause, the cells may be enlarged or have ovoid shape.
Images: The area of central pallor is elongated and which can give a mouth-like or slit-like appearance to the cell – the stoma. Note that the cell may have an ovoid shape in some conditions and that the stromal slit may sometimes be shaped like a Y. Infrequent stomatocytes can arise on almost any blood film, and always consider whether they have arisen as an artefact. Where frequent, the context, size and frequency of the abnormal forms is central to their interpretation (see causes).
Significance
First exclude artefact (slow film drying), then consider the number of these cells - occasional stomatocytes may arise in many conditions. However, when present in significant number stomatocytes may indicate significant acquired or inherited disease signifying one of a range of conditions (including liver disease, alcohol, or electrolyte imbalance). However, also consider a range of inherited conditions (see table) or look for the characteristic very large and oval-shaped often with a Y-shaped stoma that are seen in South East Asian Ovalocytosis (see images).
Pitfalls
The distinctive appearance means that morphological confusion with other forms is unlikely. Be aware however that the appearance may arise as an artefact of prolonged film drying.
Causes
| Artefact |
|---|
| Poor film preparation: caused by excess water on slide |
| Acquired conditions with occasional stomatocytes |
| Seen as part of the spectrum of abnormal cells in acquired haemolysis |
| Occasional cells present in blood films showing dyserythropoiesis from a range of causes |
| Acquired conditions with frequent stomatocytes |
| Excess alcohol intake |
| Advanced liver disease |
| Inherited stomatocytosis |
| Dehydrated stomatocytosis (Xerocytosis: stomatocytes infrequent or absent). Due to potassium loss (mild stomatocytosis with macrocytosis and in vitro hperkaemaemia). |
| Overhydrated stomatocytosis (Hydrocytosis: stomatocytes frequently greater than 20%) Due to potassium and sodium influx (haemolysis generally mild). |
| South East Asian Ovalocytosis |
| Look for the typical very enlarged and ovoid stomatocytes that may have a Y-shaped cleft. |
Clinical Examples
Clinical Image 1: Typical stomatocytes note the central slit-like stoma replacing the usual area of central pallor.
Clinical Image 2: Many typical stomatocytes with a central slit-like stoma replacing the usual area of central pallor. In this case most of the abnormal cells are normal sized or slightly microcytic, note the transition between normal cell and stmatocyte in some cells as the area of central pallor becomes more elongated. Clinical condition: hereditary stomatocytosis.
Clinical Image 3: Stomatocytosis is prominent with a significant variability in cell size with some quite large examples. The stoma can also be quite complex in this condition with a “Y-shaped” stoma being a feature of some cells. Clinical condition: South East Asian ovalocytosis.
Pathobiology
Stomatocytes are believed to arise because of an expansion of the inner layer of their lipid membrane (the precise opposite of echinocytes). This causes affected circulating cells to have a “cup-like” appearance in circulation - when flattened and dessicated on a blood film the cells appear to have a slit like opening - the “stoma” (try squashing a paper cup vertically). The inherited stomatocytoses arise from altered cation permiability with either a net influx of sodium causing swelling of the erythrocyte (overhydrated hereditary stomatocytosis), or a net eflux of potassium causing fragile stomatocytes (dehydrated hereditary stomatocytosis).